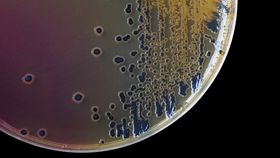

Here’s something you never realized you need to worry about: space germs. New research suggests that our immune systems would have an extremely hard time detecting and responding to germs from other planets.
The rest of this article is behind a paywall. Please sign in or subscribe to access the full content.Of course, this is all hypothetical. Your chances of coming into contact with an extraterrestrial microorganism in the near future are slim; scientists have still never gathered any direct evidence of life outside of Earth. However, the research does hold some important implications for space missions and humanity’s bold plans to colonize other planets.
"The world is now only too aware of the immune challenge posed by the emergence of brand new pathogens," Professor Neil Gow, deputy vice-chancellor (Research and Impact) at the University of Exeter, explained in a statement.
"As a thought experiment, we wondered what would happen if we were to be exposed to a microorganism that had been retrieved from another planet or moon where life had evolved,” he added. “Would our immune system be able to detect proteins made from these non-terrestrial building blocks if such organisms were discovered and were brought back to Earth and then accidentally escaped?”
Reported in the journal Microorganisms, scientists from the universities of Aberdeen and Exeter in the UK looked to see how mice, whose immune cells function in a similar way to those of humans, respond to components that are likely to be found in so-called exo-microorganisms from beyond Earth.
The researchers examined the reaction of T cells, important soldiers of the immune system, to peptides containing amino acids, such as isovaline and α-aminoisobutyric acid. These amino acids have been found in high abundance on meteorites, but are extremely rare in the tissues of organisms on Earth, so the researchers argue these would be a good proxy to understand how a mammal’s body might react to alien microorganisms.
The immune response appeared to be notably weaker to the exo-peptides. Although T cells were still activated by the exo-peptides, their response was less efficient compared to their reaction to more typical Earth-bound peptides. Activation levels of 15 percent and 61 percent were seen against isovaline and α-aminoisobutyric acid, compared to 82 percent and 91 percent activation levels when exposed to peptides made entirely of amino acids that are common on Earth.
"Our investigation showed that these exo-peptides were still processed, and T cells were still activated, but these responses were less efficient than for 'ordinary' Earth peptides,” added Dr Katja Schaefer, lead author from the University of Exeter.
"We, therefore, speculate that contact with extra-terrestrial microorganisms might pose an immunological risk for space missions aiming to retrieve organisms from exoplanets and moons."
As Professor Gow mentioned, the past few months have made it clear how dangerous a novel pathogen can be, but be under no illusion: the coronavirus responsible for Covid-19 did not come to Earth on a meteorite (as some British tabloids have suggested).
“The most compelling evidence that SARS-CoV-2 didn’t come from a meteorite is that it is so closely related to other known coronaviruses,” Dr Dominic Sparkes, a specialist in infectious diseases, told IFLScience in February. “It’s closely related to the SARS (severe acute respiratory syndrome) virus that caused an outbreak in the early 2000s and the MERS (Middle Eastern respiratory syndrome) virus which still causes disease currently.”